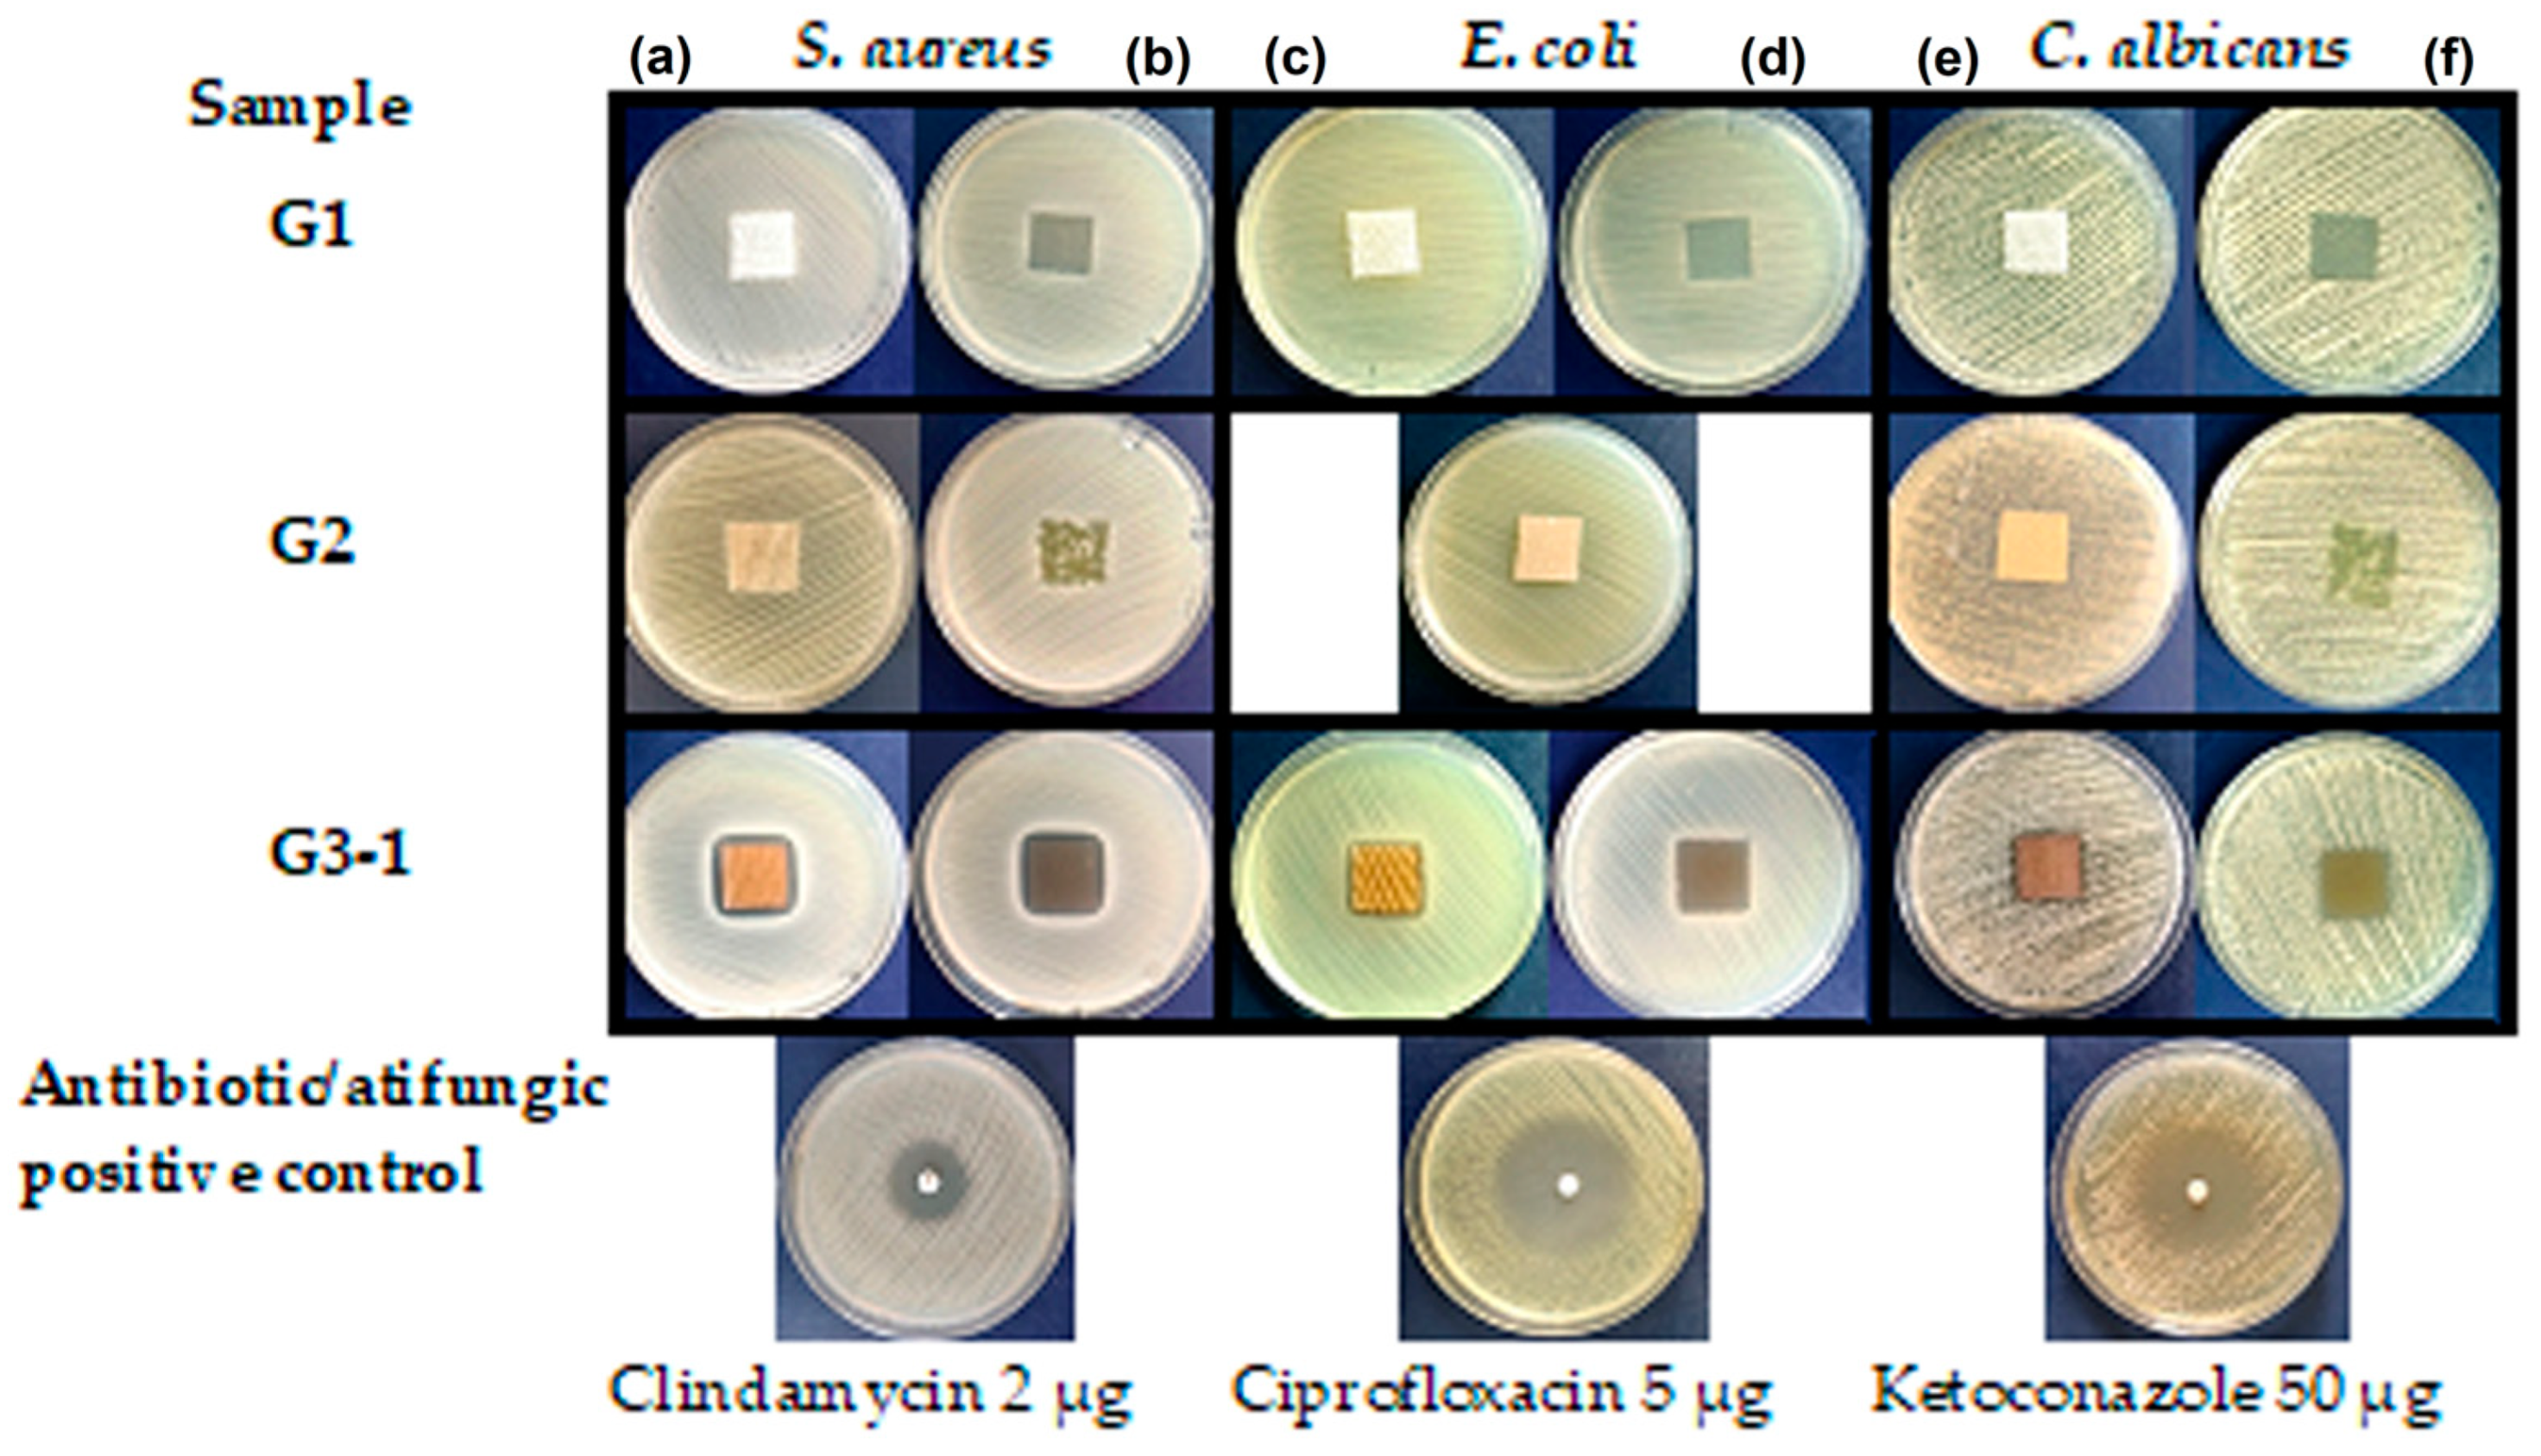
Gels 10 00106 g008
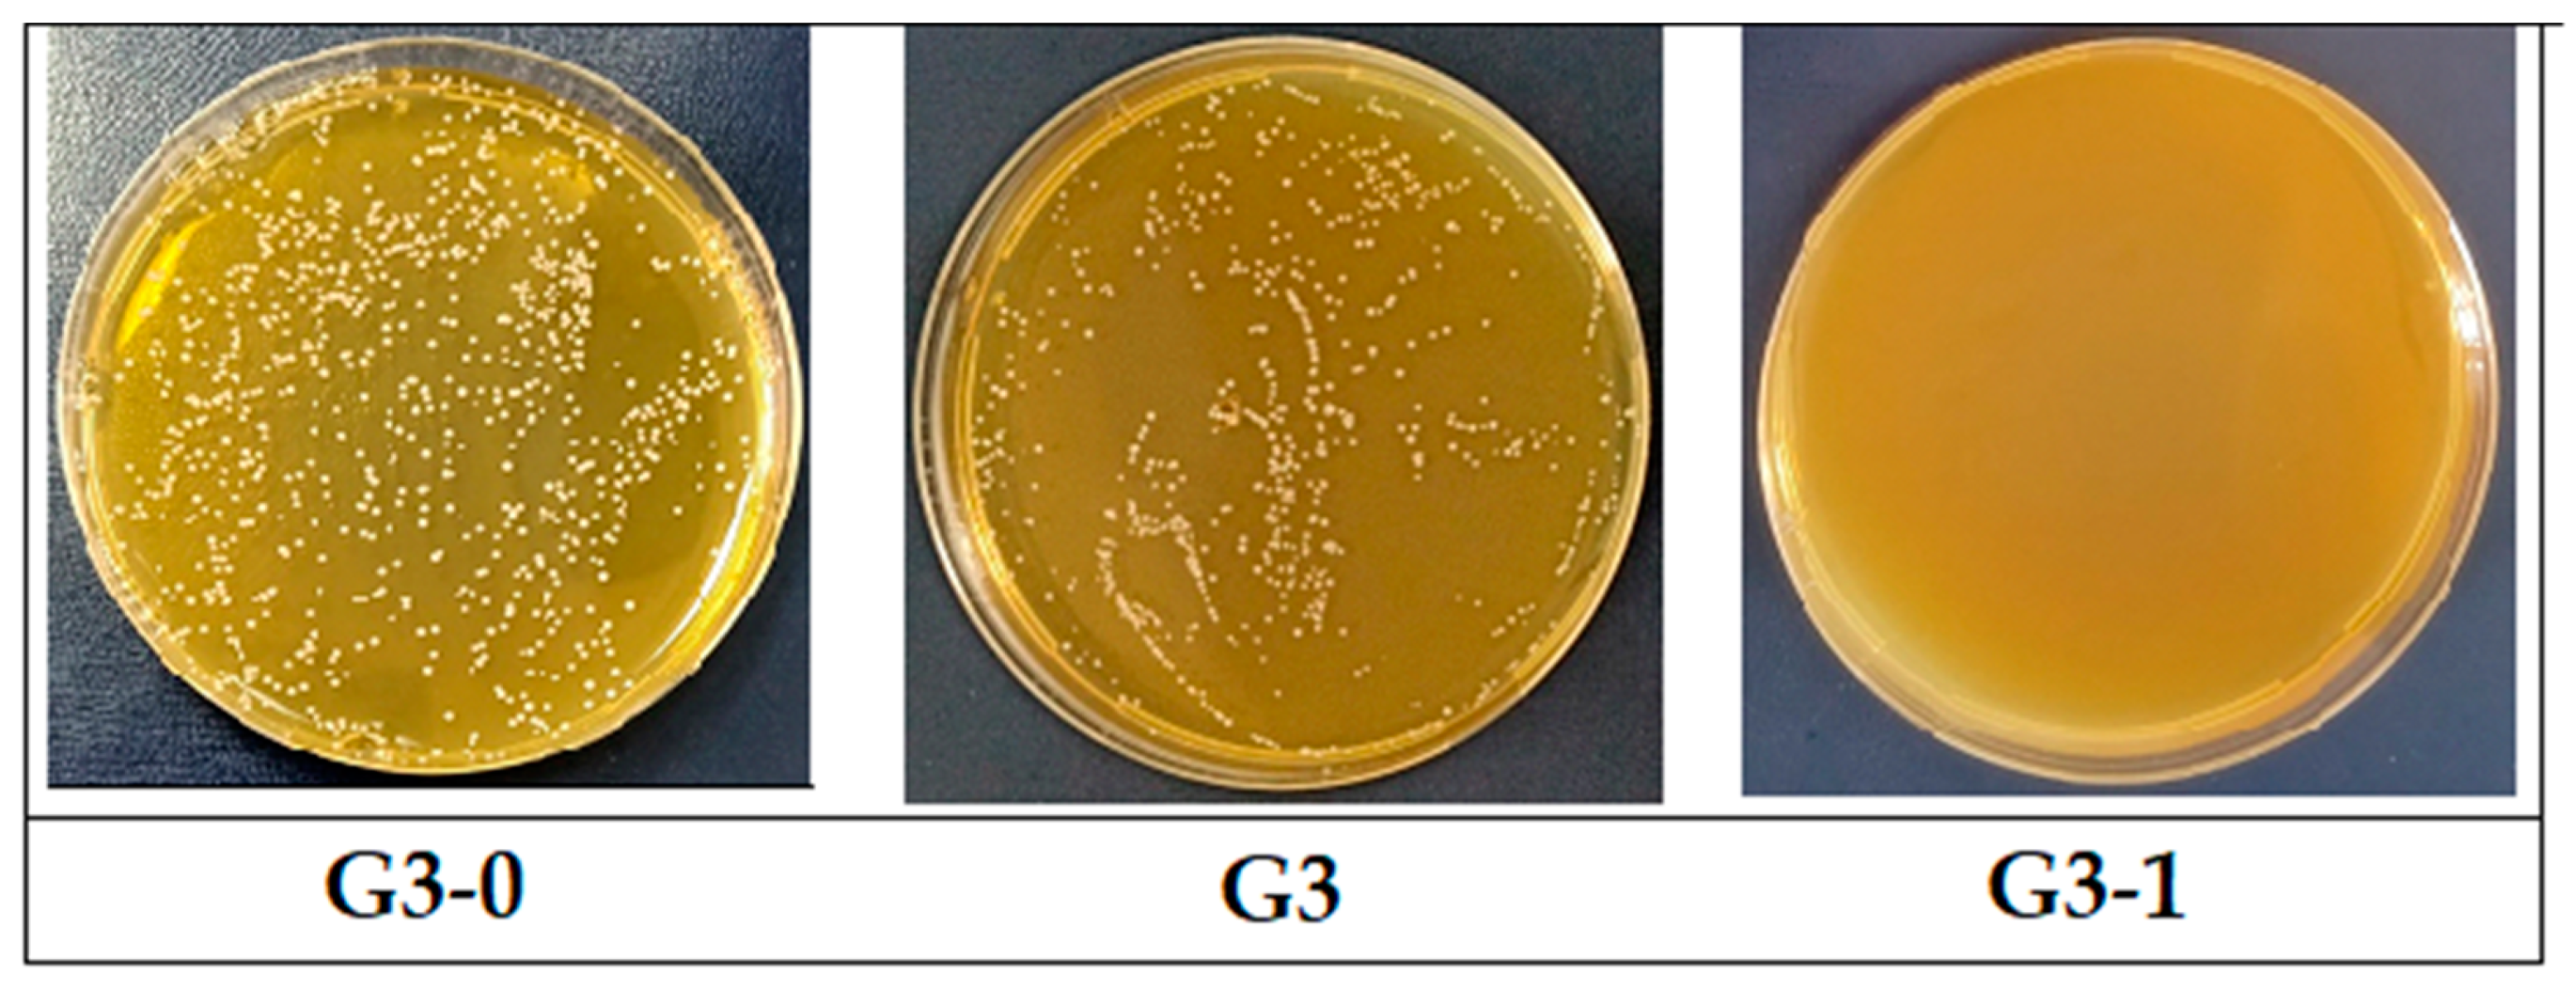
Gels 10 00106 g010

Ag0–Ginger Nanocomposites Integrated into Natural Hydrogelated Matrices Used as Antimicrobial Delivery Systems Deposited on Cellulose Fabrics
Abstract
1. Introduction
2. Results and Discussion
2.1. Characterization of the Cellulose Fabrics Finished with Natural Hydrogels
2.1.1. FTIR Spectroscopy
2.1.2. X-ray Diffraction Analysis of Fabrics Finished with Hydrogel Matrices
2.1.3. SEM-EDX Analysis of Fabrics Finished with Hydrogel Matrices
2.1.4. Thermogravimetric Analysis
2.1.5. Color Parameters in CIEL*a*b* System and Water Contact Angle Measurements
2.2. Spectrophotometric Determination of Silver Ions by the Dithizone Method
2.3. Antimicrobial Study
3. Conclusions
4. Materials and Methods
4.1. Materials
4.2. Methods
Author Contributions
Funding
Institutional Review Board Statement
Informed Consent Statement
Data Availability Statement
Acknowledgments
Conflicts of Interest
References
- Tang, K.W.K.; Millar, B.C.; Moore, J.E. Antimicrobial Resistance (AMR). Br. J. Biomed. 2023, 80, 11387. [Google Scholar] [CrossRef]
- Salam, M.A.; Al-Amin, M.Y.; Salam, M.T.; Pawar, J.S.; Akhter, N.; Rabaan, A.A.; Alqumber, M.A.A. Antimicrobial Resistance: A Growing Serious Threat for Global Public Health. Healthcare 2023, 11, 1946. [Google Scholar] [CrossRef]
- Bassetti, M.; Garau, J. Current and future perspectives in the treatment of multidrug-resistant Gram-negative infections. J. Antimicrob. Chemother. 2021, 76, 23–37. [Google Scholar] [CrossRef]
- Karaiskos, I.; Lagou, S.; Pontikis, K.; Rapti, V.; Poulakou, G. The “Old” and the “New” Antibiotics for MDR Gram-Negative Pathogens: For Whom, When, and How. Front. Public Health 2019, 7, 151. [Google Scholar] [CrossRef]
- Sperandio, F.F.; Huang, Y.Y.; Hamblin, M.R. Antimicrobial photodynamic therapy to kill Gram-negative bacteria. Recent Pat. Anti-Infect. Drug Discov. 2013, 8, 108–120. [Google Scholar] [CrossRef]
- Lorenzo-Leal, A.C.; Tam, W.; Kheyrandish, A.; Mohseni, M.; Bach, H. Antimicrobial Activity of Filtered Far-UVC Light (222nm) against Different Pathogens. BioMed Res. Int. 2023, 8, 2085140. [Google Scholar] [CrossRef]
- Yi, H.; Yuan, G.; Li, S.; Xu, X.; Guan, Y.; Zhang, L.; Yan, Y. Drug Combinations to Prevent Antimicrobial Resistance: Various Correlations and Laws, and Their Verifications, Thus Proposing Some Principles and a Preliminary Scheme. Antibiotics 2022, 11, 1279. [Google Scholar] [CrossRef]
- Parmanik, A.; Das, S.; Kar, B.; Bose, A.; Dwivedi, G.R.; Pandey, M.M. Current Treatment Strategies Against Multidrug-Resistant Bacteria: A Review. Curr. Microbiol. 2022, 79, 388. [Google Scholar] [CrossRef]
- Gyawali, R.; Ibrahim, S.A. Natural products as antimicrobial agents. Food Control 2014, 46, 412–429. [Google Scholar] [CrossRef]
- Beristain-Bauza, S.D.C.; Hernández-Carranza, P.; Cid-Pérez, T.S.; Ávila-Sosa, R.; Ruiz-López, I.I.; Ochoa-Velasco, C.E. Antimicrobial Activity of Ginger (Zingiber Officinale) and Its Application in Food Products. Food Rev. Int. 2019, 35, 407–426. [Google Scholar] [CrossRef]
- Farid, N.; Waheed, A.; Motwani, S. Synthetic and natural antimicrobials as a control against food borne pathogens: A review. Heliyon 2023, 9, 17021. [Google Scholar] [CrossRef] [PubMed]
- Raduly, F.M.; Raditoiu, V.; Raditoiu, A.; Purcar, V. Curcumin: Modern Applications for a Versatile Additive. Coatings 2021, 11, 519. [Google Scholar] [CrossRef]
- Matlock, A.; Garcia, J.A.; Moussavi, K.; Long, B.; Liang, S.Y.T. Advances in novel antibiotics to treat multidrug-resistant gram-negative bacterial infections. Intern. Emerg. Med. 2021, 16, 2231–2241. [Google Scholar] [CrossRef]
- Bhatt, S.; Pathak, R.; Punetha, V.D.; Punetha, M. Recent advances and mechanism of antimicrobial efficacy of graphene-based materials: A review. J. Mater. Sci. 2023, 58, 7839–7867. [Google Scholar] [CrossRef] [PubMed]
- Yılmaz, G.E.; Göktürk, I.; Ovezova, M.; Yılmaz, F.; Kılıç, S.; Denizli, A. Antimicrobial Nanomaterials: A Review. Hygiene 2023, 3, 269–290. [Google Scholar] [CrossRef]
- Karypidis, M.; Karanikas, E.; Papadaki, A.; Andriotis, E.G. A Mini-Review of Synthetic Organic and Nanoparticle Antimicrobial Agents for Coatings in Textile Applications. Coatings 2023, 13, 693. [Google Scholar] [CrossRef]
- Technology and Innovation for Cleaner and More Productive and Competitive Production. Available online: www.unctad.org (accessed on 20 December 2023).
- Coccia, M. New technological trajectories to reduce fossil-fuel pollution and support sustainable socioeconomic systems. Res. Sq. 2022. [Google Scholar] [CrossRef]
- Söderholm, P. The green economy transition: The challenges of technological change for sustainability. Sustain. Earth 2020, 3, 6. [Google Scholar] [CrossRef]
- Leichtweis, M.G.; Oliveira, M.B.P.P.; Ferreira, I.C.F.R.; Pereira, C.; Barros, L. Sustainable Recovery of Preservative and Bioactive Compounds from Food Industry Bioresidues. Antioxidants 2021, 10, 1827. [Google Scholar] [CrossRef]
- Messinese, E.; Pitirollo, O.; Grimaldi, M.; Milanese, D.; Sciancalepore, C.; Cavazza, A. By-Products as Sustainable Source of Bioactive Compounds for Potential Application in the Field of Food and New Materials for Packaging Development. Food Bioprocess. Technol. 2023, 6, 1–22. [Google Scholar] [CrossRef]
- Vaishnavee, G.J.; Deepu, S. A Review of Natural Binders as Pharmaceutical Excipient in The Novel Drug Delivery System. IJPPR Hum. Human. 2021, 21, 84–99. [Google Scholar]
- Ruschhaupt, P.; Varzi, A.; Passerini, S. Natural Polymers as Green Binders for High-Loading Supercapacitor Electrodes. ChemSusChem 2020, 13, 763–770. [Google Scholar] [CrossRef]
- Lacoste, C.; El Hage, R.; Bergeret, A.; Corn, S.; Lacroix, P. Sodium alginate adhesives as binders in wood fibers/textile waste fibers biocomposites for building insulation. Carbohydr. Polym. 2018, 184, 1–8. [Google Scholar] [CrossRef]
- Xiong, R.; Grant, A.M.; Ma, R.; Zhang, S.; Tsukruk, V.V. Naturally-derived biopolymer nanocomposites: Interfacial design, properties and emerging applications. Mater. Sci. Eng. 2018, 125, 1–41. [Google Scholar] [CrossRef]
- Sharma, P.; Sharma, S.; Ramakrishna, G.; Srivastava, H.; Gaikwad, K. A comprehensive review on leguminous galactomannans: Structural analysis, functional properties, biosynthesis process and industrial applications. Crit. Rev. Food Sci. Nutr. 2021, 62, 443–465. [Google Scholar] [CrossRef]
- Suklaew, P.O.; Chusak, C.; Adisakwattana, S. Physicochemical and Functional Characteristics of RD43 Rice Flour and Its Food Application. Foods 2020, 9, 1912. [Google Scholar] [CrossRef]
- Amagliani, L.; O’Regan, J.; Kelly, A.L.; O’Mahony, J.A. Chemistry, structure, functionality and applications of rice starch. J. Cereal Sci. 2016, 70, 291–300. [Google Scholar] [CrossRef]
- Raya, M.A.A.; Ghoneem, G.A.A.; Blasim, H.A. Effect of Addition Corn Flour on Chemical, Physical, Rheological and Sensory Properties of Iraq Bread. J. Food Dairy Sci. 2022, 13, 95–100. [Google Scholar] [CrossRef]
- Wang, L.; Zhu, F.; Lu, D. Rheological properties of sodium alginate and xanthan pastes on cotton with reactive dye in screen printing. Text. Res. J. 2013, 83, 1873–1884. [Google Scholar] [CrossRef]
- Abdou, E.S.; El-Hennawi, H.M.; Ahmed, K.A. Preparation of Novel Chitosan-Starch Blends as Thickening Agent and Their Application in Textile Printing. J. Chem. 2013, 8, 595810. [Google Scholar] [CrossRef]
- Ebrahim, S.A.; Hassabo, A.G.; Osman, H.A. Natural Thickener in Textile Printing. J. Text. Color. Polym. Sci. 2021, 18, 55–64. [Google Scholar] [CrossRef]
- Geetha, R.; Sankari, A.; Pugalendhi, L.; Vennila, P.; Swarnapriya, R.; Thangamani, C. Studies on functional properties of cassava var. Yethapur Tapioca-2 for its suitability as an ideal industrial substitute for the grain starches. J. Pharm. Innov. 2021, 10, 9–12. [Google Scholar]
- Ikram, A.; Khalid, W.; Zafar, K.W.; Ali, A.; Afza, M.F.; Aziz, A.; Rasool, I.F.; Al-Farga, A.; Aqlan, F.; Koraqi, H. Nutritional, biochemical, and clinical applications of carob: A review. Food Sci. Nutr. 2023, 11, 3641–3654. [Google Scholar] [CrossRef]
- Al-Awwadi, N.A.J. Potential health benefits and scientific review of ginger. J. Pharmacogn. Phytother. 2017, 9, 111–116. [Google Scholar] [CrossRef]
- Venkatadri, B.; Shanparvish, E.; Rameshkumar, M.R.; Arasu, M.V.; Al-Dhabi, N.A.; Ponnusamy, V.K.; Agastian, P. Green synthesis of silver nanoparticles using aqueous rhizome extract of Zingiberofficinale and Curcuma longa: In-vitro anti-cancer potential on human colon carcinoma HT-29 cells. Saudi J. Biol. Sci. 2020, 27, 2980–2986. [Google Scholar] [CrossRef] [PubMed]
- Vanlalveni, C.; Lallianrawna, S.; Biswas, A.; Selvaraj, M.; Changmai, B.; Rokhum, S.L. Green synthesis of silver nanoparticles using plant extracts and their antimicrobial activities: A review of recent literature. RSC Adv. 2021, 11, 2804. [Google Scholar] [CrossRef] [PubMed]
- El-Refai, A.A.; Ghoniem, G.A.; El-Khateeb, A.Y.; Hassaan, M.M. Eco-friendly synthesis of metal nanoparticles using ginger and garlic extracts as biocompatible novel antioxidant and antimicrobial agents. J. Nanostruct. Chem. 2018, 8, 71–81. [Google Scholar] [CrossRef]
- Parihar, A.; Vongsvivut, J.; Bhattacharya, S. Synchrotron-Based Infra-Red Spectroscopic Insights on Thermo-Catalytic Conversion of Cellulosic Feedstock to Levoglucosenone and Furans. ACS Omega 2019, 4, 8747–8757. [Google Scholar] [CrossRef]
- Ishikawa, D.; Yang, J.; Ichikawa, C.; Fujii, T. Evaluation of solid state of rice flours produced by different milling processes using ATR-FTIR spectroscopy. Biosci. Biotechnol. Biochem. 2021, 85, 1056–1062. [Google Scholar] [CrossRef]
- Costaa, H.S.; Dias, M.R. Alginate/Bioactive Glass Beads: Synthesis, Morphological and Compositional Changes Caused by SBF Immersion Method. Mater. Res. 2021, 24, e20200587. [Google Scholar] [CrossRef]
- Christou, C.; Agapiou, A.; Kokkinofta, R. Use of FTIR spectroscopy and chemometrics for the classification of carobs origin. J. Adv. Res. 2018, 10, 1–8. [Google Scholar] [CrossRef]
- Erceg, T.; Stupar, A.; Cvetinov, M.; Vasi, V.; Risti, I. Investigation the correlation between chemical structure and swelling, thermal and flocculation properties of carboxymethylcellulose hydrogels. J. Appl. Polym. Sci. 2021, 138, 50240. [Google Scholar] [CrossRef]
- Fawcett, T.G.; Crowder, C.E.; Kabekkodu, S.N.; Needham, F.; Kaduk, J.A.; Blanton, T.N.; Petkov, V.; Bucher, E.; Shpanchenko, R. Reference materials for the study of polymorphism and crystallinity in cellulosics. Powder Diffr. 2013, 28, 18–31. [Google Scholar] [CrossRef]
- Eskens, O.; Villani, G.; Amin, S. Rheological Investigation of Thermoresponsive Alginate-Methylcellulose Gels for Epidermal Growth Factor Formulation. Cosmetics 2021, 8, 3. [Google Scholar] [CrossRef]
- Urbanova, M.; Pavelkova, M.; Czernek, J.; Kubova, K.; Vyslouzil, J.; Pechova, A.; Molinkova, D.; Vyslouzil, J.; Vetchy, D.; Brus, J. Interaction Pathways and Structure—Chemical Transformations of Alginate Gels in Physiological Environments. Biomacromolecules 2019, 20, 4158–4170. [Google Scholar] [CrossRef]
- Aydın, S.; Özdemir, Y. Development and Characterization of Carob Flour Based Functional Spread for Increasing Use as Nutritious Snack for Children. J. Food Qual. 2017, 7, 5028150. [Google Scholar] [CrossRef]
- Glowacki, E.D.; Irimia-Vladu, M.; Bauerb, S.; Sariciftci, N.S. Hydrogen-bonds in molecular solids—From biological systems to organic electronics. J. Mater. Chem. B 2013, 1, 3742. [Google Scholar] [CrossRef]
- Raduly, F.M.; Rădițoiu, V.; Rădițoiu, A.; Frone, A.N.; Nicolae, C.A.; Răut, I.; Constantin, M.; Grapin, M. Multifunctional Finishing of Cotton Fabric with Curcumin Derivatives Coatings Obtained by Sol-Gel Method. Gels 2023, 9, 369. [Google Scholar] [CrossRef] [PubMed]
- Fleischmann, C.; Lievenbrück, M.; Ritter, H. Polymers and Dyes: Developments and Applications. Polymers 2015, 7, 717–746. [Google Scholar] [CrossRef]
- ISO 105-X12; ISO Textiles—Tests for Colour Fastness—Part X12: Colour Fastness to Rubbing. International Organization for Standardization: Geneva, Switzerland, 2016.
- Shah, R.; Devi, S. Spectrophotometric determination of microquantities of silver(I) using dithizone in the presence of cetyltrimethylammonium bromide. Indian J. Chem. 1995, 34, 925–927. [Google Scholar]
- Pinho, E.; Magalhães, L.; Henriques, M.; Oliveira, R. Antimicrobial activity assessment of textiles: Standard methods comparison. Ann. Microbiol. 2011, 61, 493–498. [Google Scholar] [CrossRef]
- Ivankovic, T.; Rajic, A.; Ercegovic, R.S.; du Roscoat, R.S.; Skenderi, Z. Antibacterial Properties of Non-Modified Wool, Determined and Discussed in Relation to ISO 20645:2004 Standard. Molecules 2022, 27, 1876. [Google Scholar] [CrossRef] [PubMed]

| Element | Line Type | G1 Weight% | G2 Weight % | G3 Weight % |
|---|---|---|---|---|
| C | K series | 26.68 | 26.96 | 26.72 |
| O | K series | 72.03 | 72.03 | 71.82 |
| S | K series | - | - | 0.20 |
| Mg/Na | K series | 0.06 | - | 0.28 |
| Ca | K series | 0.41 | 0.20 | 0.25 |
| Ag | L series | 0.56 | 0.61 | 0.52 |
| P | K series | 0.07 | - | 0.07 |
| Cl | K series | - | - | 0.07 |
| K | K series | - | 0.20 | 0.07 |
| Sample | Color Parameters | Rubbing Fastness (Grade) ISO 105 X12 | Water Contact Angle (Standard Deviation) | |||
|---|---|---|---|---|---|---|
| L* | a* | b* | Dry | Wet | (°) | |
| Cotton fabric | 82.94 | −0.07 | −1.14 | – | – | 0 |
| Rice flour | 90.51 | −0.57 | 3.44 | – | – | – |
| G1 | 68.01 | 2.62 | 4.77 | 2–3 | 1–2 | 107 ± 9.67 |
| Alginate | 63.68 | 9.13 | 21.64 | – | – | – |
| G2 | 68.81 | 5.76 | 7.04 | 3 | 2–3 | 75 ± 10.02 |
| Carob flour | 83.50 | 4.69 | 21.45 | – | – | – |
| G3 | 76.42 | 1.89 | 3.63 | 3–4 | 2–3 | 85 ± 3.60 |
| Sample | Growth of Bacteria/Fungi under the Specimen | ||
|---|---|---|---|
| S. aureus | E. coli | C. albicans | |
| G1 | none/slight | none/slight | slight |
| G2 | heavy | moderate/heavy | moderate/heavy |
| G3 | none | none/slight | none |
Disclaimer/Publisher’s Note: The statements, opinions and data contained in all publications are solely those of the individual author(s) and contributor(s) and not of MDPI and/or the editor(s). MDPI and/or the editor(s) disclaim responsibility for any injury to people or property resulting from any ideas, methods, instructions or products referred to in the content. |
© 2024 by the authors. Licensee MDPI, Basel, Switzerland. This article is an open access article distributed under the terms and conditions of the Creative Commons Attribution (CC BY) license (https://creativecommons.org/licenses/by/4.0/).
Share and Cite
Raduly, F.M.; Raditoiu, V.; Raditoiu, A.; Grapin, M.; Constantin, M.; Răut, I.; Nicolae, C.A.; Frone, A.N. Ag0–Ginger Nanocomposites Integrated into Natural Hydrogelated Matrices Used as Antimicrobial Delivery Systems Deposited on Cellulose Fabrics. Gels 2024, 10, 106. https://doi.org/10.3390/gels10020106
Raduly FM, Raditoiu V, Raditoiu A, Grapin M, Constantin M, Răut I, Nicolae CA, Frone AN. Ag0–Ginger Nanocomposites Integrated into Natural Hydrogelated Matrices Used as Antimicrobial Delivery Systems Deposited on Cellulose Fabrics. Gels. 2024; 10(2):106. https://doi.org/10.3390/gels10020106
Chicago/Turabian StyleRaduly, Florentina Monica, Valentin Raditoiu, Alina Raditoiu, Maria Grapin, Mariana Constantin, Iuliana Răut, Cristian Andi Nicolae, and Adriana Nicoleta Frone. 2024. "Ag0–Ginger Nanocomposites Integrated into Natural Hydrogelated Matrices Used as Antimicrobial Delivery Systems Deposited on Cellulose Fabrics" Gels 10, no. 2: 106. https://doi.org/10.3390/gels10020106
APA StyleRaduly, F. M., Raditoiu, V., Raditoiu, A., Grapin, M., Constantin, M., Răut, I., Nicolae, C. A., & Frone, A. N. (2024). Ag0–Ginger Nanocomposites Integrated into Natural Hydrogelated Matrices Used as Antimicrobial Delivery Systems Deposited on Cellulose Fabrics. Gels, 10(2), 106. https://doi.org/10.3390/gels10020106








